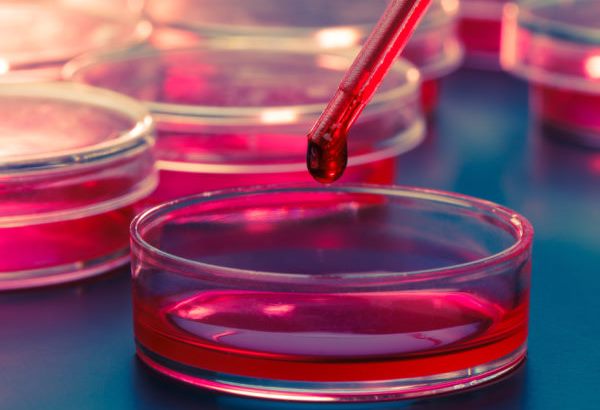
خونگیری آزمایش پرولاکتین

آزمایش پرولاکتین یا آزمایش PRL برای اندازه گیری مقدار هورمون پرولاکتین که توسط غده هیپوفیز در خون تولید می شود، می باشد. غده هیپوفیز خانم غیرباردار و آقایان پرولاکتین تولید می کند اما دلیل تولید آن در بدن هنوز مشخص نیست. این آزمایش در کسانی انجام می شود که مشکوک به بالا بودن پرولاکتین باشند . یعنی خروج شیر از سینه (گالاکتوره )، تاخیر در پریود ، اختلالات بینایی و …داشته باشد. در این مقاله به همه پرسش های شما در مورد پرولاکتین و آزمایش آن پاسخ داده میشود:
شرایط آزمایش پرولاکتین
داروهای موثر بر میزان پرولاکتین
آزمایش پرولاکتین روز چندم پریود؟
آیا برای آزمایش پرولاکتین باید پریود بود؟
خواندن جواب آزمایش پرولاکتین
رنج نرمال پرولاکتین
پرولاکتین چند خطرناکه
ایا بالا بودن پرولاکتین مانع بارداری میشود
هزینه آزمایش پرولاکتین
هورمون پرولاکتین چیست؟
خانم باردارمقدار زیادی پرولاکتین دارد که به تولید شیر در سینه کمک می کند. در طول بارداری مقدار پرولاکتین ده تا بیست برابر افزایش می یابد. بعد از تولد فرزند، اگر شیردهی انجام شود سطح پرولاکتین بالا می ماند. در خانم هایی که فرزند را شیر نمی دهند، بعد از تولد مقدار پرولاکتین به سطح نرمال برمی گردد. بعد از چند ماه شیردهی نیز مقدار پرولاکتین به سطح نرمال می رسد (حتی اگر شیردهی ادامه داشته باشد).
مقدار پرولاکتین در طول روز متغیر می باشد. بیشترین مقدار در هنگام خواب و مدت کوتاهی بعد از بیداری می باشد. همچنین در هنگام استرس های احساسی و فیزیکی نیز سطح پرولاکتین افزایش می یابد. بیشتر داروها باعث افزایش مقدار پرولاکتین می شوند. تومورهای غده هیپوفیز گاهی باعث افزایش مقدار پرولاکتین می شوند. یک غده هیپوفیز آسیب دیده نمی تواند مقدار نرمالی پرولاکتین تولید کند به همین دلیل مقدار آن کاهش می یابد.
دلیل انجام آزمایش پرولاکتین
آزمایش پرولاکتین به دلایل زیر انجام می شود:
- برای تعیین دلیل ترشحات غیرطبیعی پستان، پریود نشدن خانم یا باردار نشدن خانم
- در آقایان هنگامی که احتمال وجود مشکل در غده هیپوفیز باشد، این آزمایش انجام می شود. همچنین هنگامی که تمایل جنسی در مرد کم باشد یا در هنگام نعوظ مشکل وجود داشته باشد، برای بررسی مقدار پرولاکتین، آزمایش انجام می شود. همچنین هنگامی که مقدار تستوسترون در آقایان پایین است نیز این آزمایش انجام می شود.
همچنین برای بررسی این که تومور موجود در غده هیپوفیز، پرولاکتین زیادی تولید می کند یا خیر، این آزمایش انجام می شود [1]
شرایط آزمایش پرولاکتین
1- پیش از انجام آزمایش پرولاکتین ، به مدت چند ساعت چیزی نخورید (نه غذا و نه نوشیدنی).
2- آزمایش پرولاکتین معمولا سه ساعت بعد از بیدار شدن شما انجام می شود (بین ساعت هشت و ده صبح).
3- استرس احساسی یا ورزش های تنش زا پیش از انجام آزمایش، باعث افزایش سطح پرولاکتین می شوند. بنابراین پزشک از شما می خواهد نیم ساعت استراحت کنید.
4- تحریک نوک پستان باعث افزایش مقدار پرولاکتین می شود. بیست و چهار ساعت پیش از انجام آزمایش پرولاکتین، از تحریک کردن نوک پستان بپرهیزید. خانمی که ترشحات نوک پستان دارد، پیش از آزمایش باید از عواملی که باعث افزایش ترشحات می شود اجتناب کند.
5- در شب قبل از آزمایش لباس گشاد و راحت بپوشند و از پوشیدن لباس های تنگ خصوصا درناحیه سینه و پستان ها اجتناب گردد.
6- استرس در زمان انجام آزمایش خصوصاً در طی 30 دقیقه پیش از آن موجب نتایج اشتباه میشود، از اینرو بیماران باید استرس خود را در زمان آزمایش به حداقل برسانند.
7- معاینه و نیز تحریک پستانها طی 24 ساعت قبل، موجب اشتباه در نتیجه آزمایش میشوند.
داروهای موثر بر میزان پرولاکتین
داروهایی مانند استروژن، داروهای ضد افسردگی سه حلقه ای، خواب آورها، آمفتامین ها، داروهای ضد بارداری- دارو های مخدر مثل هروئین , متادون، داروهای فشار خون بالا (رزرپین، وراپامیل، متیل دوپا) و برخی از داروهایی که برای درمان ریفلاکس معده (سایمتیدین و رانتیدین) استفاده می شوند، باعث افزایش پرولاکتین می شوند.
گیاهانی مثل شنبلیله، تخم رازیانه و شبدر قرمز نیز باعث افزایش پرولاکتین می شوند. داروهایی مانند دوپامین، لوودوپا و مشتقات آلکالوئیدهای ارگو باعث کاهش پرولاکتین می شوند.
پزشک اقدامات زیر را انجام می دهد:
- یک باند الاستیک بالای بازوی شما می بندد تا جلوی جریان خون را بگیرد. این کار باعث بزرگ تر شدن رگ های پایین باند می شود بنابراین فرو کردن آمپول در رگ آسان تر می شود.
- قسمتی که آمپول فرو می شود را با الکل تمیز می کند.
- آمپول را داخل رگ می کند. ممکن است چند سوزن مورد نیاز باشد.
- مقداری خون از رگ کشیده می شود.
- هنگامی که به اندازه کافی خون گرفته شد، باند را باز می کند.
- یک پد گاز استریل یا پنبه بر روی دست شما، قسمتی که سوزن وارد شد، قرار می دهد.
- بر روی دست فشار وارد میکند سپس آن را با باند می بندد.
آزمایش پرولاکتین روز چندم پریود؟
آزمایش پرولاکتین نیز مانند سایر آزمایشات هورمونی در روز سوم پریود انجام شود. بصورت ناشتا باشید.
آیا برای آزمایش پرولاکتین باید پریود بود؟
شما آزمایش را باید در سوم پریود انجام دهید ممکن است در این زمان هنوز خونریزی ادامه داشته باشه و یا کم شده باشه و در برخی هم که دو سه روز بیشتر نیست قطع شده باشد.
خون گرفتن طی آزمایش پرولاکتین
نمونه برداری از دست شما انجام می شود. باند دور دست سفت بسته می شود. ممکن است هیچ چیزی حس نکنید یا یک ضربه سریع یا نیش زدن سریع در هنگام فرو کردن سوزن حس کنید.
خطرات خون گرفتن طی آزمایش پرولاکتین
احتمال خطر در هنگام خون گرفتن خیلی کم است.
-
ممکن است کبودی کوچکی در قسمت فرو کردن آمپول ایجاد شود. احتمال ایجاد کبودی خیلی کم است.
-
در موارد نادر امکان دارد رگ بعد از خون گرفتن، ورم کند. برای حل این مشکل کیسه آب گرم چند بار در روز بر روی رگ قرار می دهند.
- در افرادی که مشکلات خونی دارند امکان بند نیامدن خون وجود دارد. قرص هایی مانند آسپرین، وارفارین و قرص های رقیق کننده خون باعث ایجاد این مشکل می شوند. اگر مشکل لخته شدن خون دارید یا قرص رقیق کننده خون مصرف می کنید پیش از انجام آزمایش به پزشک اطلاع دهید [2].
خواندن جواب آزمایش پرولاکتین

آزمایش پرولاکتین مقدار هورمون پرولاکتین را اندازه گیری می کند که توسط غدد هیپوفیز تولید شده و وارد خون می شود. مقدار پرولاکتین در طول روز متفاوت است. بیشترین مقدار در هنگام خواب و کمی بعد از بیدار شدن می باشد. برای تفسیر آنلاین آزمایش پرولاکتین میتوانید، اپلیکیشن سلامت اوما را نصب کنید تا متخصصین اوما نتیجه را برای شما تفسیر کنند.
سطح پایین در نتیجه آزمایش هورمون پرولاکتین:
- معمولا، درمان سطوح پایین پرولاکتین نیاز نیست ، دلیل رایج برای پایین بودنش دارو است.
- برخی از نمونه ها شامل دوپامین و لوودوپا هستند.
- در برخی موارد، سطح پایین پرولاکتین ممکن است نشانه اختلال هیپوفیز باشد.
سطح بالا در نتیجه آزمایش هورمون پرولاکتین:
این سطح پرولاکتین در خون می تواند دلایل بسیار زیادی داشته باشد.شرایط مربوط به سطح بالای هورمون پرولاکتین شامل موارد زیر است:
- اختلالات هیپوفیز
- کم کاری تیروئید
- سندرم کیست تخمدان ( PCOS )
- بیماری های کلیوی
- بیماری کبدی
- بی اشتهایی عصبی
اگر یک پزشک مظنون باشد، ممکن است سی تی اسکن یا MRI را توصیه کنند.
رنج نرمال پرولاکتین
مقادیر نرمال پرولاکتین در ادامه لیست شده است. این مقادیر در آزمایشگاه های متفاوت فرق می کند. همچنین پزشک براساس سلامتی شما و فاکتورهای دیگر این مقادیر را تعیین می کند.
در خانم های غیر باردار : 23-4 نانوگرم در هر میلی لیتر (ng/ml)
در آقایان : 15-3 نانوگرم در هر میلی لیتر (ng/ml)
خانم باردار : 386-34 نانوگرم در هر میلی لیتر(ng/ml)
کودکان : 20-3 نانوگرم در میلی لیتر(ng/ml)
اگر واحد mIU/l باشد : مقادیر بین 555-30 طبیعی است.
پرولاکتین چند خطرناکه؟
مقادیر بالای پرولاکتین به معنی وجود تومور غده هیپوفیز است. هر چقدر مقدار پرولاکتین بالاتر باشد، احتمال وجود تومور غده هیپوفیز بیشتر است. اگر مقدار پرولاکتین بیشتر از دویست نانوگرم در میلی لیتر باشد، ام آر آی انجام می شود. کم بودن یا نرمال بودن مقدار پرولاکتین به معنی نبود تومور غده هیپوفیز نمی باشد. ام آر آی در حالی که احتمال وجود تومور باشد انجام می شود.
احتمالا اکنون می پرسید که پرولاکتین چند خطرناکه؟ بالا بودن بسیار شدید پرولاکتین – تا 1000 برابر بالاتر از محدوده طبیعی- می تواند نشان دهنده ابتلا به پرولاکتینوما باشد. این تومور یا بافت های اضافه غالبا خوش خیم هستند به این معنا که سرطانی نبوده و با دارو قابل درمان می باشند. در این وضعیت ممکن است پزشک انجام یک آزمایش MRI را به شما توصیه کند. بنابراین اگر می خواهید بدانید که پرولاکتین بالای چند خطرناکه، باید به شما بگوییم اگر نتیجه آزمایشتان عدد 1000 برابر بالاتر از محدوده طبیعی را نشان می دهد لازم است به متخصص غدد مراجعه کرده و آزمایشات بیشتری را انجام دهید.
برای انجام این آزمایش ابتدا بر روی تخت MRI دراز کشیده و بعد به داخل کانال عکس برداری هدایت می شوید. سپس با استفاده از امواج رادیویی تصاویر واضح و دقیقی از مغز شما گرفته می شود. در مرحله بعد پزشک با بررسی نتایج MRI مشخص می کند که آیا در نزدیکی غده هیپوفیز توده اضافه ای وجود دارد یا خیر و یا در صورت وجود داشتن بزرگی آن چقدر است [3].
ایا بالا بودن پرولاکتین مانع بارداری میشود؟
زمانی که پرولاکتین بالا باشد مانع تخمک گذاری میشود حتی اگر پریودهای منظم داشته باشید. برای مردان، میزان بالای پرولاکتین منجر به اختلال عملکرد نادرست و ناتوانی جنسی می شود. این اثر در مردان به این دلیل است که پرولاکتین می تواند از تولید هورمون تستوسترون در مغز جلوگیری کند [4]
چه چیزی بر روی آزمایش پرولاکتین تاثیر گذار است؟
در چه شرایطی نمی توانید آزمایش را انجام دهید یا نتیجه آزمایش به درد شما نمی خورد:
- استرس احساسی زیاد یا ورزش تنش زا پیش از آزمایش انجام داده باشید.
- مشکل در خوابیدن؛ مقدار پرولاکتین در هنگام خواب افزایش می یابد. بنابراین اگر به درستی نخوابید، مقدار پرولاکتین از حد نرمال پایین تر می رود.
- تحریک نوک سینه.
- مصرف برخی قرص ها مانند قرص ضدبارداری، قرص فشار خون بالا، قرص ضد حساسیت یا قرص های روانی.
- استفاده از کوکائین.
- اگر یک هفته پیش از آزمایش پرولاکتین، آزمایش رادیواکتیو انجام داده باشید، آزمایش پرولاکتین درست نمی باشد.
چه زمانی نیاز به انجام آزمایش پرولاکتین است؟
- آقایان و خانم های غیرباردار به طور نرمال مقدار پرولاکتین کمی دارند. تنها مشکل کمبود پرولاکتین، تولید نشدن شیر بعد از بارداری می باشد. بنابراین افرادی که مقدار پایین پرولاکتین دارند نیز درمان نمی شوند.
- در هنگامی که مرد تمایل جنسی نداشته باشد یا در هنگام نعوظ مشکل داشته باشد، آزمایش پرولاکتین انجام می شود. مقدار پرولاکتین در هنگامی که مقدار تستوسترون مرد پایین است، مورد بررسی قرار می گیرد.
- درمان تومور غده هیپوفیز که منجر به تولید بیش از حد پرولاکتین می شود، شامل مصرف قرص، برداشتن غده هیپوفیز، رادیوگرافی غده می باشد. انتخاب نوع درمان به اندازه تومور و سلامتی و سن فرد بستگی دارد [5].
هزینه آزمایش پرولاکتین
هزینه انجام آزمایش پرولاکتین در مراکز مختلف با بیمه های مختلف متفاوت است اما در مراکز دولتی حدودا 84 هزار تومان می باشد.
1- Abha Majumdar and Nisha Sharma Mangal. Hyperprolactinemia. J Hum Reprod Sci. 2013 Jul-Sep; 6(3): 168–175.
2- Jeffcoate SL, Bacon RR, Beastall GH, Diver MJ, Franks S, Seth J. Assays for prolactin: guidelines for the provision of a clinical biochemistry service. Ann Clin Biochem. 1986 Nov;23 ( Pt 6):638-51.
3- Mohamed Saleem, Helen Martin and Penelope Coates. Prolactin Biology and Laboratory Measurement: An Update on Physiology and Current Analytical Issues. Clin Biochem Rev. 2018 Feb; 39(1): 3–16.
4- Matsuoka R, Mori H. The effects of pregnancy on prolactin secretion in occulted hyperprolactinemi. Nihon Sanka Fujinka Gakkai Zasshi. 1991 Dec;43(12):1617-22.
5-Freeman ME, Kanyicska B, Lerant A, Nagy G. Prolactin: structure, function, and regulation of secretion. Physiol Rev. 2000 Oct;80(4):1523-631.






